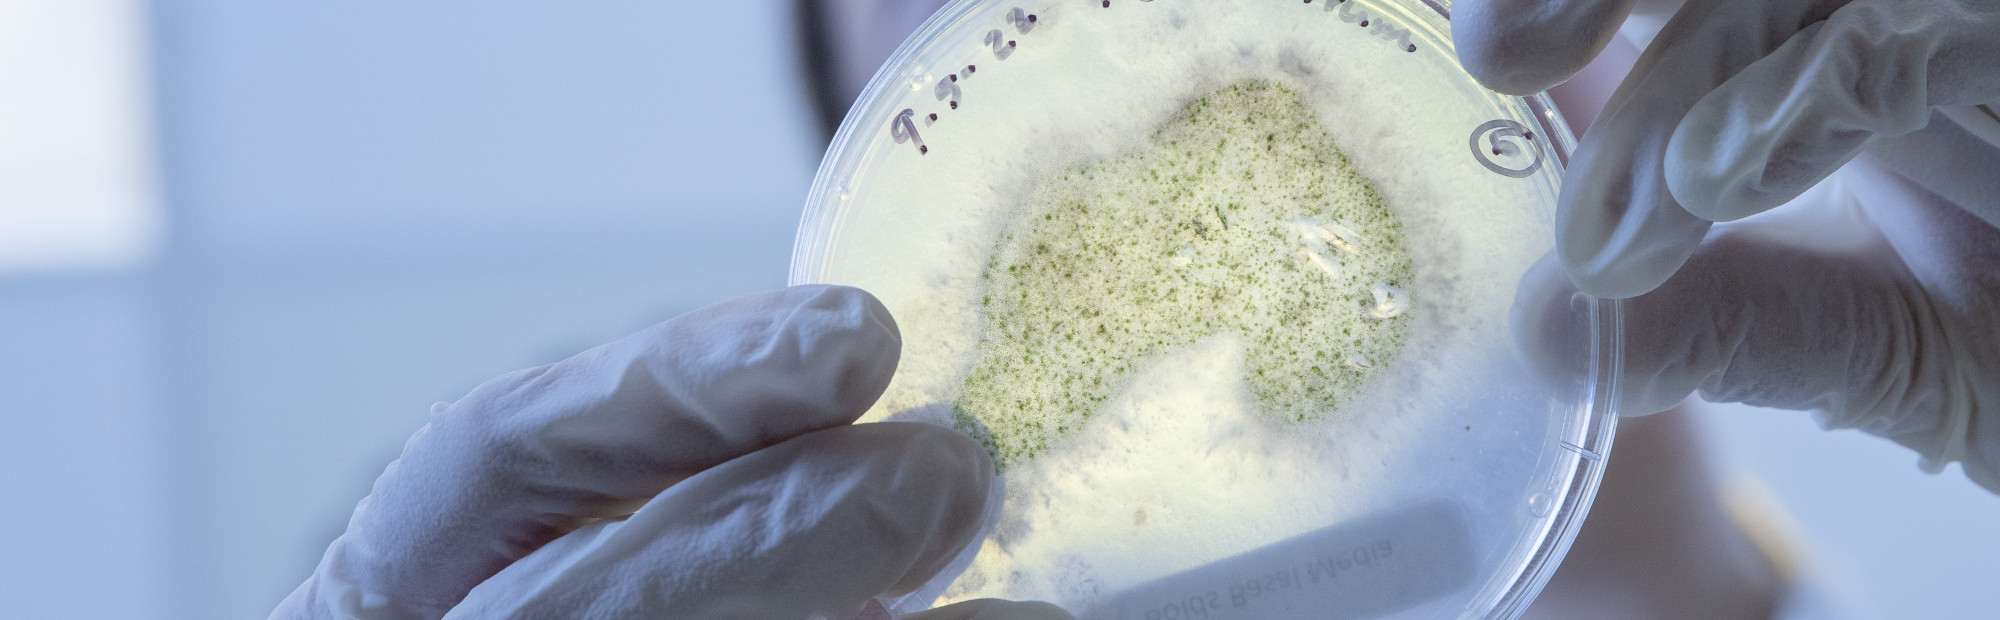

Explore biology at a school ranked top in New Zealand for its research quality.
Our world-class staff can introduce you to biomedical science, biotechnology, conservation biology, evolutionary genetics, marine biology, New Zealand’s endangered species, reproductive biology, and more.
You will also be exposed to opportunities to engage in ground-breaking international research and discovery.

Biological Sciences
Biological Science is the study of how living organisms work. Learn to apply this knowledge of living things to make life better for humans, and help the environment.
Find out moreAvailable subjects
-
Biology, Biotechnology, Cell and Molecular Bioscience, Molecular Microbiology
Biomedical Sciences
From disease prevention and treatment, to the development of new life—study Biomedical Sciences and discover how human bodies operate at the molecular, genetic, and cellular levels.
Find out moreAvailable subjects
-
Human Genetics, Molecular Pathology, Molecular Pharmacology and Medicinal Chemistry, Biomedical Science, Clinical Immunology, Clinical Research, Drug Discovery and Development

Ecology and Marine Biology
Take your passion for the natural world to the next level. Explore topics in ecology, marine biology and conservation biology and learn about the vast diversity of plants, animals and micro-organisms that live on earth.
Find out moreAvailable subjects
-
Conservation Biology, Ecological Restoration, Ecology and Biodiversity, Marine Biology, Marine Conservation
Centre for Biodiscovery
The Centre for Biodiscovery’s mission is to enhance health and wellbeing through discovery and application of nature-inspired products and processes.
Biodiversity and Restoration Ecology
The Centre for Biodiversity and Restoration Ecology focuses on the restoration of depleted species and communities in ecosystems impacted by human activity.
Coastal Ecology Laboratory
The Wellington University Coastal Ecology Laboratory in Wellington’s Island Bay supports the School of Biological Sciences’ coastal ecology research.


